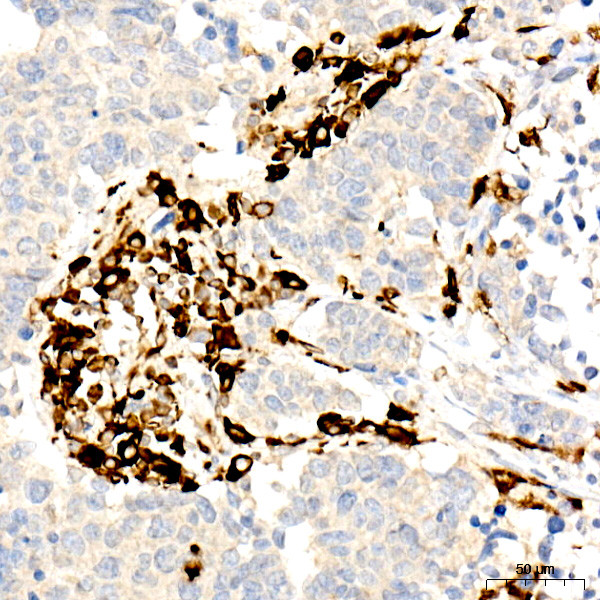
CD74 Antibody in Immunohistochemistry (Paraffin) (IHC (P))

Search
Invitrogen
CD74 Recombinant Rabbit Monoclonal Antibody (2M8H5)
{{$productOrderCtrl.translations['antibody.pdp.commerceCard.promotion.promotions']}}
{{$productOrderCtrl.translations['antibody.pdp.commerceCard.promotion.viewpromo']}}
{{$productOrderCtrl.translations['antibody.pdp.commerceCard.promotion.promocode']}}: {{promo.promoCode}} {{promo.promoTitle}} {{promo.promoDescription}}. {{$productOrderCtrl.translations['antibody.pdp.commerceCard.promotion.learnmore']}}
图: 1 / 4
CD74 Antibody (MA5-35766) in IHC (P)




Please note: We are reviewing Western blot images included in the antibody testing data in our catalog, including those provided by third parties. Unless expressly labeled or annotated as “raw-unedited”, Western blot images included in the antibody testing data in our catalog may have been edited, optimized or otherwise adjusted for presentation.
产品信息
MA5-35766
种属反应
宿主/亚型
Expression System
分类
类型
克隆号
抗原
偶联物
形式
浓度
规格
纯化类型
保存液
内含物
保存条件
运输条件
RRID
产品详细信息
Immunogen sequence: MHRRRSRSCR EDQKPVMDDQ RDLISNNEQL PMLGRRPGAP ESKCSRGALY TGFSILVTLL LAGQATTAYF LYQQQGRLDK LTVTSQNLQL ENLRMKLPKP
靶标信息
HLA-DR, like other MHC class II molecules, is a transmembrane glycoprotein composed of a 36 kDa alpha chain (DRA) and 27 kDa beta chain (DRB). The alpha chain gene contains 5 exons. Exon 1 encodes the leader peptide, exons 2 and 3 encode the two extracellular domains, and exon 4 encodes the transmembrane domain and the cytoplasmic tail. DRA does not have polymorphisms in the peptide binding part and acts as the sole alpha chain for DRB1, DRB3, DRB4 and DRB5. Within the DR molecule the beta chain contains all the polymorphisms specifying the peptide binding specificities. Hundreds of DRB1 alleles have been described and typing for these polymorphisms is routinely done for bone marrow and kidney transplantation. HLA-DR is expressed primarily on antigen presenting cells such as B lymphocytes, monocytes, macrophages, thymic epithelial cells and activated T lymphocytes. Three loci, DR, DQ and DP, encode the major expressed products of the human class II region. The human MHC class II molecules bind intracellularly processed peptides, present them to T-helper cells, and have a critical role in the initiation of the immune response.
仅用于科研。不用于诊断过程。未经明确授权不得转售。
篇参考文献 (0)
生物信息学
蛋白别名: CD74; CD74 antigen; HLA class II histocompatibility antigen gamma chain; HLA-DR antigens-associated invariant chain; Ia antigen-associated invariant chain; Ii
基因别名: CD74; DHLAG
Entrez Gene ID: (Human) 972